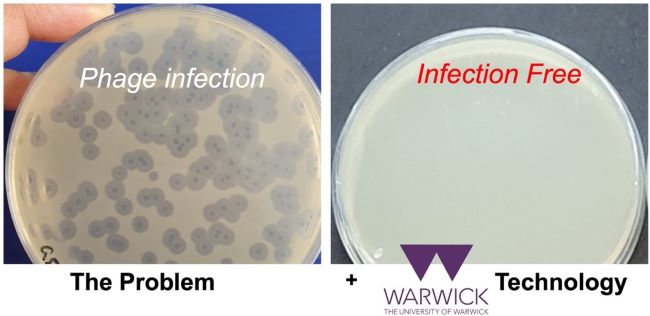
uniofwarwick's tweet image. Bacteria used in biological and biomedical research can become contaminated with viruses, causing significant down-time in research and industrial processes. New research has found that a polymer can prevent these phage infections.

Read more: warwick.ac.uk/newsandevents/…

Evangelos Vryonis
@evryonis
Infection Doctor
You might like
An example of how a psychiatrist can be a useful part of the MDT for patients with autoimmunity. Not just long covid. That patients will engage with. Not go away feeling they've been told they are anxious or its in their head. Fascinating case studies x.com/sanilrege/stat…
ME/ CFS & Long Covid Overlap - WHY? - Grab a cup of☕️ and Let's go back in time 📷 (25 min video) "In history, a great volume is unrolled for our instruction, drawing the materials of future wisdom from the past errors and infirmities of mankind". So, In this video, I take…
The Use of Long-Term Antibiotics for Suppression of Bacterial Infections ✅ Just Accepted bit.ly/3ySEPKx
WikiGuidelines Group Creates Guidelines for Diagnosis, Management of Infective Endocarditis in Adults pharmacytimes.com/view/wikiguide… via @Pharmacy_Times
Four recent insights suggest the need for more refined methods to assess the resistogenicity of doxycycline post exposure prophylaxis sciencedirect.com/science/articl… #OpenAccess

We've just presented and published a multicenter RCT at #CCR23 and in @JAMA_current! Continuous vs Intermittent Meropenem Administration in Critically Ill Patients with Sepsis: The #MERCYtrial! 🔗 jamanetwork.com/journals/jama/… This 🧵 will explain the study in detail /11 #FOAMcc

Very pleased that our new paper is out! pubs.acs.org/doi/10.1021/ac… Excellent work from Josh @MIBTP1 and Jaimee (Mbio @WarwickLifeSci ) in collaboration with @Chen_group . Thanks to @BBSRC for funding!
pubs.acs.org
Genetic Engineering of Bacteriophage K1F with Human Epidermal Growth Factor to Enhance Killing of...
Bacterial infections are a major cause of human morbidity and mortality on a global scale. Many bacterial pathogens, such as Escherichia coli, can cause diseases intracellularly via cell entry and...
We have engineered a phage that targets E.coli (K1F) to express human EGF. We present that this recombinant phage can be internalized easier in human cell lines, targets intracellular E. coli K1 more efficiently and enters human cells mainly via endocytosis unlike the WT.
@JKozdryk @danhoward_ortho @FoguetPedro @evryonis @timpetheram @mikereednhs @Jeya_Palan @Outcomes_PROMs @BAJIR_UK @mikepetrie4 @mikereednhs @rhidianmj
If you have a passion for orthopaedic infections, please consider joining the newly formed and @BritOrthopaedic affiliated Bone and Joint Infection Society - visit BAJIS.org #UKPJI Exeter 23 #orthopaedicinfection

Breakout session for @BAJIR_UK and @BAJIS_UK 5 minutes in and already loving it and the ideas coming from it...


@BAJIR_UK delighted to be here in Exeter representing our Registry Currently at the first formal @BAJIS_UK formal steering meeting of the new Bone and Joint Infection Society Hearing about the new web site where you can sign up for membership bajis.org

Do take a look at the website of this exciting new society and consider joining this group if you have an interest in orthopaedic infection @BAJIS_UK
Announcing this year’s UKPJI conference in Exeter on June 15-16 Register online: clockworkmedical.com/ukpji/ Should be a great meeting with a mix of specialities including Ortho and Micro/ID

Bacteria used in biological and biomedical research can become contaminated with viruses, causing significant down-time in research and industrial processes. New research has found that a polymer can prevent these phage infections. Read more: warwick.ac.uk/newsandevents/…
Standardized protocol for using phage therapy @Iredell_Lab @ECCMID #ECCMID2023 #phagetherapy bmjopen.bmj.com/content/bmjope…

Fascinating talk on dx of PJI from the guru Prof Patel. Lots of food for thought for how we can improve pathogen detection #ECCMID23

United States Trends
- 1. Happy Friday the 13th N/A
- 2. Good Friday N/A
- 3. #RISERCONCERTD1 N/A
- 4. BTS IS BACK N/A
- 5. RED Friday N/A
- 6. #BTSxGQMagazine N/A
- 7. Crew-12 N/A
- 8. #GenshinSpecialProgram N/A
- 9. JASPER KINDLED FIRSTRISE N/A
- 10. Happy Friyay N/A
- 11. #FridayFeeling N/A
- 12. Palestine Action N/A
- 13. Brent N/A
- 14. Arson N/A
- 15. International Space Station N/A
- 16. Jill Scott N/A
- 17. Chibi N/A
- 18. hudson N/A
- 19. Falcon 9 N/A
- 20. Zimbabwe N/A
You might like
Something went wrong.
Something went wrong.





















































































































